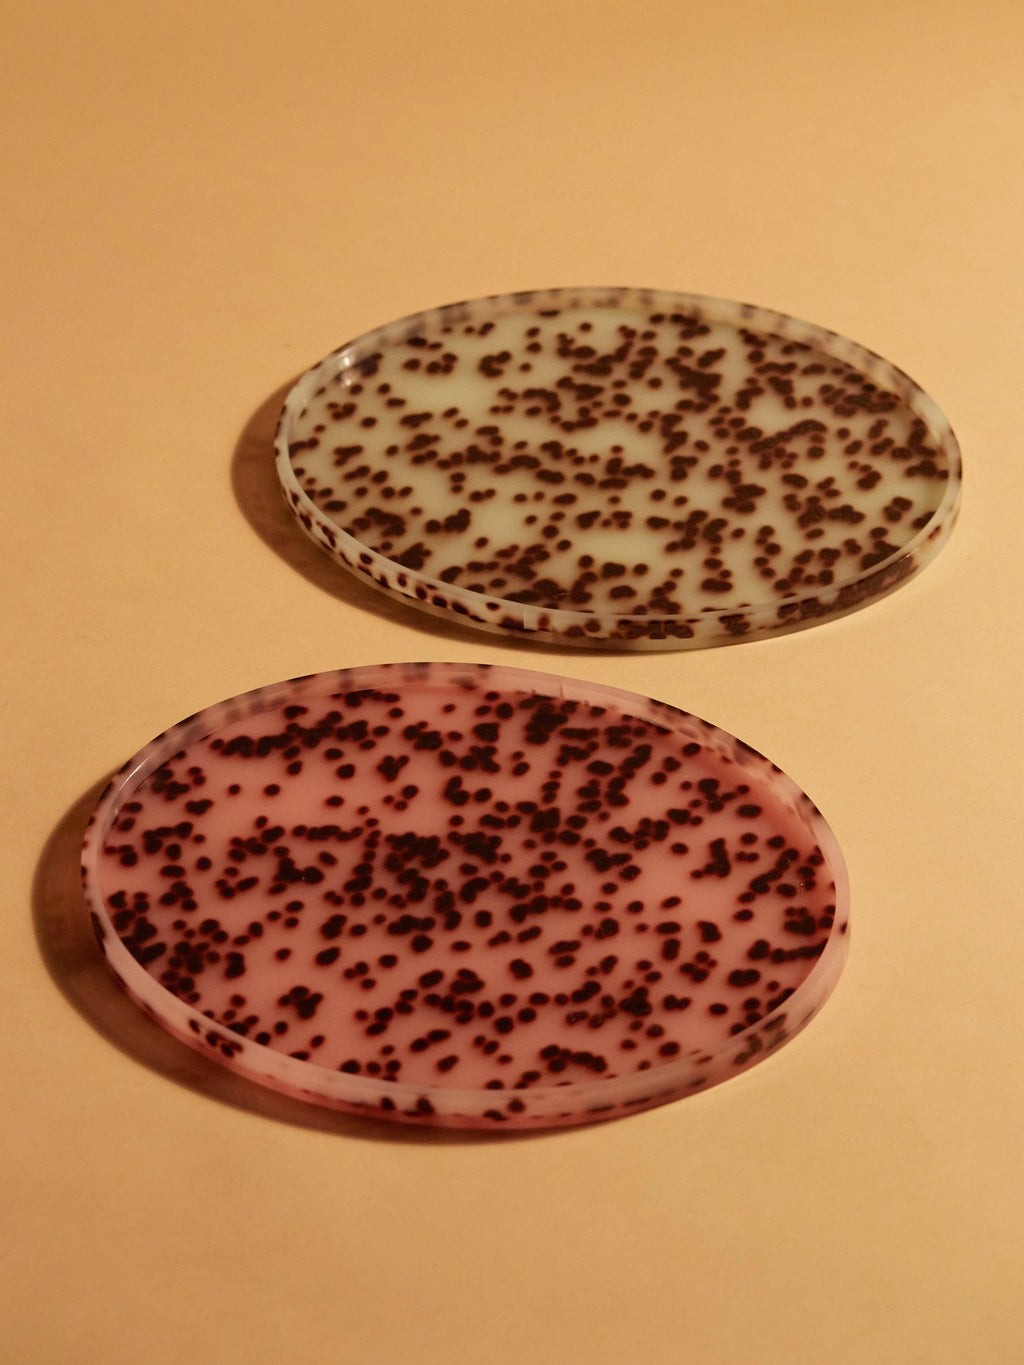
Oval Tray Turquoise Spot - Reliquia Jewellery

Passer aux informations sur le produit


Plateau Ovale Tache Turquoise
$249.00
Le marbrage unique est la pièce maîtresse de ces plateaux ovales décoratifs.
Disponible également en pois roses.
Résine acrylique coulée à la main.
Dimensions : 24 x 31 x 1,7 cm